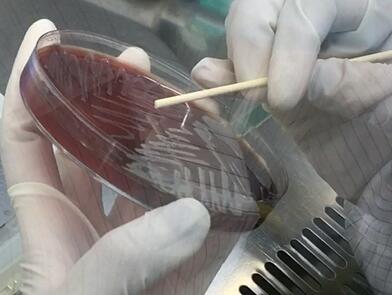

Professional Factory Discount Price Maldi-tof Microbial Mass Spectrometry System Medical Supplies
(0
评论)
估计运输时间:
3 天
价格:
$157,800.00
/Pc
退款:
分享:
畅销产品
Products Description

item | value |
Type | Blood & Gas Analysis System |
Brand Name | Meihua |
Model Number | MD100 |
Place of Origin | China |
Guangdong | |
Instrument classification | Class II |
Warranty | 2 years |
After-sale Service | Online technical support |
Product name | MALDI-TOF |
Customized support | oem & odm |
Brand Name | Meihua |
Packing Measurement | 75x80x140CM |
Product show







Related Products

Company Profile


Transport Logistics


FAQ

Q: How to purchase your products ?
A: Please inform us your detailed requirement or demand, we will offer some recommendation. After your confirmation, we will issue a formal proforma invoice (PI) for your final confirmation and payment. You can purchase from us directly or via Alibaba Trade Assurance Order.
Q: What's the warranty for the products ?
A: The standard warranty is one year from the date of arrival. In addition, we will still provide good after-sales service after warranty period.
Q: What kind of after-sales service include?
A: Online Technical Support, other remote technical support; Spare part support, Training, Field Service if requested
Q: Can we visit your factory ?
A: Of course, welcome to visit our factory if you come to China.
Q: What's the production date after we confirm the order ?
A: This depends on the quantity and specific requirement. Normally, for the mass production, we need about 35-40 days to finish the production. For some regular reagents, we can provide within 7 days after the confirmation.
Q: Is OEM or ODM service available
A: Available upon request.
该产品暂无评论。




















